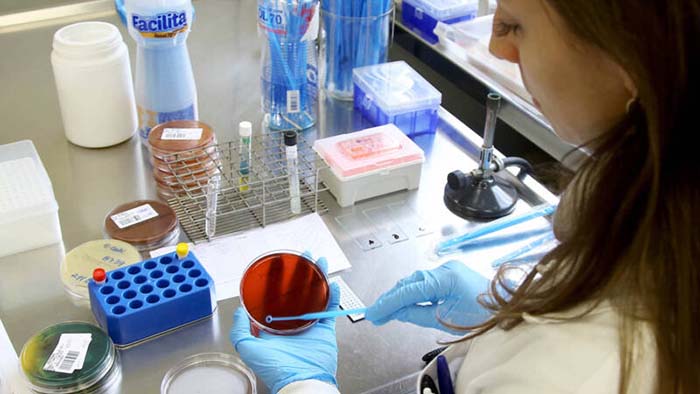

USP, Unesp e Unicamp formam 25% menos mestres e doutores na pandemia
ISABELA PALHARES
O número de titulações de mestrado e doutorado nas três universidades estaduais paulistas caiu 25% durante a pandemia. Juntas, em 2021, as instituições formaram 5.600 mestres e 3.623 doutores, num total de 9.223 titulações, o menor número dos últimos dez anos – em 2011, foram 9.925. USP, Unicamp e Unesp são responsáveis por formar quase um terço dos mestres e doutores do Brasil. Ainda que não haja números nacionais disponíveis sobre o total de concluintes nas demais instituições de ensino nos últimos dois anos, a queda nas três universidades mais representativas acende alerta para uma possível retração em todo o país.
Segundo as pró-reitorias de pós-graduação, a queda se explica em parte pela extensão de prazos para a defesa das teses durante a pandemia. Mas também é reflexo da redução de financiamento para a ciência no país nos últimos anos.
O total de mestres formados pelas três universidades paulistas, em 2021, foi 25,4% menor que o registrado em 2019, antes da pandemia, quando foram 7.505 titulações. O total de novos doutores caiu 24% neste período – em 2019, elas registraram 4.721 títulos nessa etapa. “O andamento das pesquisas sofreu um impacto muito significativo com a pandemia e o isolamento. Apesar do esforço para continuar com as aulas e as bancas de qualificação no sistema remoto, algumas etapas, como as investigações em campo, uso de laboratório, tiveram que ser paralisadas”, diz Marcio de Castro Silva Filho, pró-reitor pro tempore de Pós-Graduação da USP.
Doutorando da Escola de Enfermagem da USP, Dionasson Marques precisou pedir prorrogação de seis meses para concluir sua tese, já que a pandemia o forçou a mudar a metodologia de pesquisa. Ele coletava dados em unidades de saúde sobre o uso de álcool por mulheres e, com o isolamento, a abordagem presencial teve que ser substituída pelo telefone. “A prorrogação foi essencial, porque tive que mudar a metodologia. Foi um período muito difícil. Eu ainda quero seguir para o pós-doutorado, mas o contexto da ciência no país é muito desanimador. Quero continuar pela minha formação, mas sinto que não há valorização”, diz.
Segundo a USP, cerca de 50% dos pós-graduandos pediram prorrogação de prazo, o que deve fazer com que os números dos próximos anos ainda continuem abaixo do que vinha sendo registrado antes da pandemia. O pró-reitor destaca que, nesse mesmo período, os programas de pós-graduação da universidade tiveram queda de 20% de ingressantes.
Silva Filho atribui a queda à falta de apoio financeiro aos estudantes. Além de cada vez mais escassas no país, as bolsas de estudos das agências federais, que são a principal fonte de financiamento para quem vai fazer uma pós-graduação, não são reajustadas desde 2013. Mestrandos recebem R$ 1.500, e doutorandos, R$ 2.200. “São nove anos sem reajuste de inflação, a bolsa é hoje muito pouco atrativa. Ela não é suficiente para manter os estudantes, principalmente em cidades maiores e com maior custo de vida. O aluno desiste de ingressar na graduação porque sabe que não terá apoio financeiro”, diz.
Na Unesp, o número de títulos nas duas modalidades caiu 15% em dois anos. Para Maria Valnice Boldrin, pró-reitora de Pós-Graduação, a queda é resultado do estrangulamento da ciência no país, e a redução pode ser ainda maior neste e no próximo ano. “Mestrado e doutorado em instituições de ponta, como as nossas, exigem dedicação exclusiva, por isso, as bolsas são tão importantes. Sem elas, o estudante vai ter que trabalhar para se manter. Se o país enxergasse a pesquisa com o valor devido, entenderia que é um trabalho em tempo integral, e a remuneração dos pesquisadores seria maior.”
Na Unesp, só 36% dos doutorandos e mestrandos recebem algum tipo de bolsa. Nos últimos cinco anos, a universidade teve corte de 30% nas bolsas que recebia pelo CNPq (Conselho Nacional de Desenvolvimento Científico e Tecnológico), órgão do governo federal.
Na Unicamp, o total de defesas de teses de mestrado e doutorado caiu 25% desde o início da pandemia. A pró-reitora Rachel Meneguello diz que a queda não foi provocada por abandono dos cursos, mas pela extensão dos prazos e também um reflexo da redução de ingressantes pré-pandemia, quando o financiamento da ciência se tornou mais escasso.
Entre 2015 e 2020, a Unicamp sofreu uma diminuição média de 15% nas bolsas de pós-graduação. “A política de desafeição à educação, ciência e cultura do governo federal, com os cortes de financiamento às agências e ministérios, está certamente afetando o ensino e a pesquisa em todas as universidades brasileiras”, diz.
Ainda que as três universidades paulistas vivam momento de retração na pós-graduação, os pró-reitores avaliam que as instituições ainda têm uma situação mais protegida do que as do restante do país. Em São Paulo, contam com o financiamento da pesquisa pela Fapesp (Fundação de Amparo à Pesquisa do Estado de São Paulo), ainda que com amplitude do que as agências federais. “Com certeza, universidades em estados que contam apenas com as agências federais estão sofrendo muito mais para manter sua produção científica”, diz Silva Filho.
A Capes (Coordenação de Aperfeiçoamento de Pessoal de Nível Superior), ligada ao Ministério da Educação e responsável pelo maior número de bolsas ofertadas no país, ainda não tem um balanço sobre o número de títulos de mestrado e doutorado nos últimos dois anos.
Desde o ano passado, o Brasil está sem um Plano Nacional de Pós-Graduação. Até agora, nem sequer foi nomeada uma comissão para para elaborar o próximo plano. A presidente da Capes, Cláudia de Toledo, é responsável por indicar integrantes que irão compor a comissão.
Em nota, a agência de fomento disse que “vários nomes, com amplo reconhecimento da comunidade científica, estão sendo consultados para compor essa comissão, que deverá ser divulgada em breve”. Não informou qual a previsão para a nomeação e nem para a conclusão do plano.
A Capes também defendeu que tem para 2022 orçamento maior do que o de 2021, o que irá garantir a “continuidade de todas as ações” e assegura o “pagamento das bolsas de pós-graduação do país”. Segundo a agência, o orçamento subiu para R$ 3,8 bilhões, um aumento de 27% em relação ao ano passado, quando era de R$ 3,01 bilhões.
Ainda assim, o valor é muito inferior ao orçamento que a Capes tinha há dez anos. Levantamento da SBPC (Sociedade Brasileira para o Progresso da Ciência) mostra que a agência teve R$ 5,13 bilhões disponível em 2012. O CNPq (Conselho Nacional de Desenvolvimento Científico e Tecnológico) também perdeu quase metade do orçamento nesse período, passando de R$ 2,04 bilhões para R$ 1,3 bilhão.










